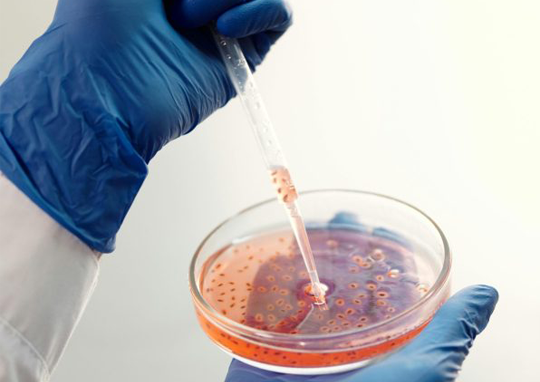

In a competitive and fast-evolving marketplace, your product’s safety and performance determine how confidently it can enter the market. Skillsphere International provides comprehensive product testing solutions that help businesses meet regulatory requirements, achieve consistent quality, and earn customer trust. From food-related assessments to advanced quality evaluations, our team ensures your products are fully compliant, safe, and ready for consumers.
WHY CHOOSE SKILLSPHERE INTERNATIONAL
Our highly trained specialists use modern testing technologies and industry-leading practices to deliver accurate, dependable results. Every assessment is carried out with precision, ensuring your product meets essential quality, durability, and safety benchmarks.
We continuously monitor national and international standards, helping your business stay ahead of regulatory changes. Partnering with Skillsphere International means gaining a dependable ally dedicated to strengthening your product integrity and boosting your market credibility. Our commitment to excellence reinforces trust both within your organization and among your customers.
OUR SERVICES
Microbiological Testing
Safety is the foundation of any successful product. Skillsphere International offers advanced microbiological testing to help you identify and manage potential contamination risks before they reach consumers. Our modern laboratory processes and strict testing protocols ensure your products comply with the highest hygiene and safety standards, delivering the confidence your brand deserves.